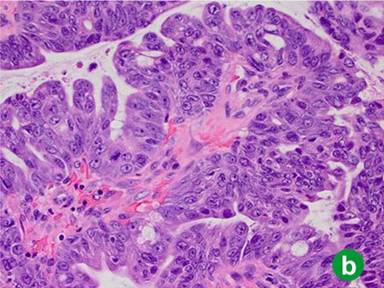

CASE REPORT
JOP. J Pancreas (Online) 2013 Jan 10; 14(1):77-80.
Intraductal Oncocytic Papillary Neoplasm of the Pancreas: Report of a Case Requiring Completion Pancreatectomy
Max V Wohlauer1, Martine McManus2, Norio Fukami3, Csaba Gajdos1
1Section of GI, Tumor and Endocrine Surgery, Department of Surgery, 2Division of Gastrointestinal Pathology, Department of Pathology, 3Division of Gastroenterology and Hepatology, Department of Medicine; University of Colorado at Denver. Aurora, CO, USA
ABSTRACT
Context Cystic tumors of the pancreas have been diagnosed with increasing frequency. Intraductal oncocytic papillary neoplasm is a rare type of cystic pancreatic tumor. Intraductal oncocytic papillary neoplasm is considered a distinct entity with the potential of developing into invasive carcinoma and it should be differentiated from other cystic tumors of the pancreas, including mucinous cystic neoplasm and other forms of intraductal papillary mucinous neoplasm (IPMN). Histologically, the formation of oncocytic cells and the complex morphology of the papillae distinguish intraductal oncocytic papillary neoplasm from IPMN. While the number of publications addressing the diagnosis, management and follow-up of patients with IPMN has been increasing, the behavior differences between IPMN and intraductal oncocytic papillary neoplasm have not been elucidated, secondary to very limited clinical experience. Case report Here, we are presenting a case of a patient with the diagnosis of intraductal oncocytic papillary neoplasm of the pancreas developing into invasive cancer. Conclusion This case stresses the necessity for lifelong surveillance of the remnant pancreas following partial pancreatectomy for intraductal oncocytic papillary neoplasm, due to the risk of developing multifocal disease.
INTRODUCTION
Cystic tumors of the pancreas are being diagnosed with increasing frequency. Intraductal oncocytic papillary neoplasm is a rare type of cystic pancreatic tumor that was first described by Adsay et al. [1]. Intraductal oncocytic papillary neoplasm is considered a distinct entity with the potential of developing into invasive carcinoma and it should be differentiated from other cystic tumors of the pancreas, including mucinous cystic neoplasm and other forms of intraductal papillary mucinous neoplasm (IPMN). Histologically, the formation of oncocytic cells and the complex morphology of the papillae distinguish intraductal oncocytic papillary neoplasm from IPMN. While the number of publications addressing the diagnosis, management and follow-up of patients with IPMN has been increasing, the behavior differences between IPMN and intraductal oncocytic papillary neoplasm have not been elucidated, secondary to very limited clinical experience. For IPMN, lifelong surveillance of the remnant pancreas following partial pancreatectomy is necessary, due to the risk of developing multifocal disease over time; however, the natural history of intraductal oncocytic papillary neoplasm remains poorly understood due to lack of long term follow-up data [2, 3]. Herein we present a patient who developed invasive intraductal oncocytic papillary neoplasm requiring completion pancreatectomy, four years following distal pancreatectomy/splenectomy for a cystic neoplasm in the tail of the pancreas.
CASE REPORT
Our patient, a 53-year-old African-American female, was evaluated and operated on at an outside facility for cystic lesion in the tail of the pancreas in 2007. The patient originally presented to an outside hospital with vague abdominal pain. Her preoperative work-up included a CT scan and ERCP with biopsies of the pancreatic cystic lesion with indeterminate results. Open distal pancreatectomy, splenectomy, cholecystectomy and bilateral oophorectomies were performed. The histology report from the outside hospital was remarkable for IPMN with a positive resection margin of focally invasive carcinoma. All 17 lymph nodes removed during the surgery were negative for cancer. A second surgery was scheduled during the same hospitalization, with an additional margin taken from the pancreas negative for residual tumor.
Fourteen months after the initial surgery, the patient was noted to have an elevated CA-19.9 level (75 U/mL: reference range: 0-37 U/mL), with main pancreatic duct dilation in the head of the pancreas on MRCP. Progressive main pancreatic duct dilation on MRCP and further elevation of CA-19.9 (133 U/mL) were noted 6 months later. Twenty-eight months after the original pancreas resection, the patient was referred to the University of Colorado for further management. A pancreas protocol CT scan showed diffuse heterogeneous enhancement of the head of the pancreas with marked main pancreatic duct dilation, measuring up to 1.7 cm in diameter, which was a new finding compared to previous studies (Figure 1a). Endoscopic ultrasound and endoscopic retrograde cholangiopancreatography examinations showed complete pancreas divisum; the ventral pancreatic duct in the head of the pancreas and pancreatic duct in the body of the pancreas were dilated markedly and diffusely. The entire opacified area contained a filling defect thought to be intraductal growth. The focal, large papillary growth within a mucin-filled dilated pancreas duct was biopsied, showing diffuse high grade dysplasia arising in the setting of suspected IPMN. A PET scan revealed a hypermetabolic pancreatic head mass with an SUV of 8 (Figure 1b). Review of outside slides from the distal pancreatectomy in 2007 by one of the co-authors (M.M.) revealed intraductal oncocytic papillary neoplasm with carcinoma in situ and microinvasion present at the original resection margin, with the subsequent surgical margin free of intraductal oncocytic papillary neoplasm.

|
Figure 1. a. CT scan with postsurgical clips status post distal pancreatectomy and splenectomy followed by pancreas re-resection at an outside hospital for a microscopically positive margin. The dilated pancreatic duct is marked with a white arrow. b. PET CT image shows diffuse uptake of contrast in the head of the pancreas. |
In 2011, four years after her original presentation, we performed a classic Whipple operation with a blood loss of 550 mL. Intraoperative frozen section of the common bile duct was negative for malignancy. The postoperative course was unremarkable and the patient was discharged to home 8 days later. Pathology report showed intraductal oncocytic papillary carcinoma 9 cm in greatest diameter, with 25 negative lymph nodes and microscopically negative surgical margins. The tumor showed diffuse high grade dysplasia and architectural complexity as well as mucin-containing intraepithelial lumina (Figure 2ab). The invasive component of the tumor was confined to the pancreas, moderately differentiated, measuring 1.9 cm in greatest diameter (Figure 2c). Additionally, a somatic KRAS mutation was identified at codon 12 and consisted of c.34G>A mutation. The case was discussed at Tumor Board and patient received adjuvant gemcitabine for six months. PET scan performed 16 months after Whipple operation showed no evidence of recurrent disease.

|
Figure 2. a. Low power image (20x) illustrates intraductal papillary growth pattern with oncocytic cells arranged in complex arborizing papillae. b. High power image (40x) showing distinctive mucin-containing intraepithelial lumina, imparting a cribriform architecture. c. Low power image (20x) displaying an invasive gland adjacent to the intraductal oncocytic papillary neoplasm. |
DISCUSSION
Intraductal oncocytic papillary neoplasm is considered the least common variant of IPMN. Histologically, it is characterized by an intraductal papillary growth pattern with exuberant, arborizing papillae, cribriforming and solid areas and oncocytic cells. One distinctive feature which is considered specific for intraductal oncocytic papillary neoplasm is the presence of mucin-containing intraepithelial lumina (Figure 2b). These tumors usually express MUC1 and MUC5AC, but MUC2 expression is weak or focal. Traditionally, intraductal oncocytic papillary neoplasms have been distinguished from IPMNs by lack of KRAS gene mutations; however, by itself this test is not reliable. As demonstrated in this case, up to 17% of intraductal oncocytic papillary neoplasms harbor a KRAS mutation [4].
The clinical behavior of intraductal oncocytic papillary neoplasm can be variable. Secondary to its rarity, this entity has only been reported at the level of case reports and small series. Preoperative differentiation of intraductal oncocytic papillary neoplasm from other variants of IPMN is difficult. Intraductal oncocytic papillary neoplasm can also communicate with the main duct of the pancreas. A few previous case reports described strong fluorodeoxyglucose uptake by the lesion, even in the absence of malignancy [5]. A case series by Liszka et al. describes the potential aggressive behavior of intraductal oncocytic papillary neoplasms arising from the pancreas (4 cases) or the common bile duct (1 case). Invasive cancer was diagnosed in all five cases measuring from 2.5 to 6 cm in patients aged between 60 and 71 years of age. All patients were treated with a Whipple operation. Two patients had follow-up available, one died at 12 months, the other was alive at 30 months but diagnosed with liver metastasis, with a mean follow-up of 18 months [6].
Current data suggest that tumor-related mortality approaches 10% for patients with intraductal oncocytic papillary neoplasm [1, 6]. However, as reflected in the Liszka’s study, little is known about the natural history of intraductal oncocytic papillary neoplasm due to the lack of long term follow-up. Furthermore, there is no long term data to suggest that prognosis for invasive intraductal oncocytic papillary neoplasm is different than the prognosis for invasive IPMN, in which large series report a 5-year survival of approximately 40% [7, 8, 9].
In summary, while IPMN are considered rare, making up less than 5% of pancreatic neoplasms, intraductal oncocytic papillary neoplasm are the “rarest of the rare” pancreatic neoplasms, comprising less than 5% of all IPMNs [10, 11]. While long term follow-up data are needed, our case is unique in that it describes extended follow-up in a patient with multifocal intraductal oncocytic papillary neoplasm who developed invasive cancer requiring completion pancreatectomy four years after her original presentation. Therefore, despite limited information on clinical characteristics and behavior, intraductal oncocytic papillary neoplasm should be treated aggressively because, like IPMN, it can develop into invasive carcinoma with a poor prognosis if left untreated. This case stresses the necessity for lifelong surveillance of the remnant pancreas following partial pancreatectomy for intraductal oncocytic papillary neoplasm, due to the risk of developing multifocal disease.
Received October 18th, 2012 – Accepted October 24th, 2012
Key words Carcinoma, Pancreatic Ductal; Cystadenocarcinoma, Mucinous; Cystadenoma, Mucinous; Pancreas; Pancreatic Neoplasms
Conflicts of interest The authors have no potential conflict of interest
Correspondence
Csaba
Gajdos
Section of GI, Tumor and Endocrine Surgery
Department of Surgery
University of Colorado at Denver
12631 E 17th Ave #C307
Aurora, CO 80045
United States of America
Phone: +1-303.724.2291
Fax: +1-303.724.2733
E-mail: csaba.gajdos@ucdenver.edu
References
1. Adsay NV, Adair CF, Heffess CS, Klimstra DS. Intraductal oncocytic papillary neoplasms of the pancreas. Am J Surg Pathol 1996; 20:980-94.
2. Chari ST,YadavD, Smyrk TC, et al. Study of recurrence after surgical resection of intraductal papillary mucinous neoplasm of the pancreas. Gastroenterology. 2002;123:1500–1507.
3. Matthaei H, Norris AL, Tsiatis AC, et al. Clinicopathological characteristics and molecular analyses of multifocal intraductal papillary mucinous neoplasms of the pancreas. Ann Surg. 2012;255:326-33.
4. Xiao HD, Yamaguchi H, Dias-Santagata D, et al. Molecular characteristics and biological behaviours of the oncocytic and pancreatobiliary subtypes of intraductal papillary mucinous neoplasms. J Pathol. 2011;224:508-16.
5. Fischer MA, Donati O, Heinrich et al. Intraductal oncocytic papillary neoplasm of the pancreas: a radio-pathological case study. JOP 2010;11:49-54.
6. Liszka L, Pajak J, Zielinska E et al. Intraductal oncocytic papillary neoplasms of the pancreas and bile ducts: a description of five new cases and review based on a systemic survey of the literature. J Hepatobiliary Pancreat Sci 2010;17:246-261.
7. D'Angelica M, Brennan MF, Suriawinata AA, et al. Intraductal papillary mucinous neoplasms of the pancreas: an analysis of clinicopathologic features and outcome. Ann Surg. 2004;239:400-8.
8. Sohn TA, Yeo CJ, Cameron JL, et al. Intraductal papillary mucinous neoplasms of the pancreas: an updated experience. Ann Surg. 2004;239:788-97; discussion 797-9.
9. Murakami Y, Uemura K, Sudo T, et al. Invasive intraductal papillary-mucinous neoplasm of the pancreas: comparison with pancreatic ductal adenocarcinoma. J Surg Oncol. 2009;100:13-8.
10. Ishida M, Egawa S, Aoki T, et al. Characteristic clinicopathological features of the types of intraductal papillary-mucinous neoplasms of the pancreas. Pancreas. 2007;35:348-52.
11. Zen Y, Sasaki M, Fujii T, et al. Different expression patterns of mucin core proteins and cytokeratins during intrahepatic cholangiocarcinogenesis from biliary intraepithelial neoplasia and intraductal papillary neoplasm of the bile duct—an immunohistochemical study of 110 cases of hepatolithiasis. J Hepatol. 2006;44:350-8.